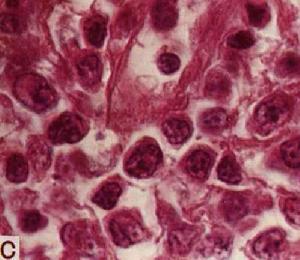
何杰金氏淋巴瘤

病因病機
(一)病因
何杰金氏淋巴瘤
何杰金氏淋巴瘤本病的病因和發病機理尚不十分清楚,可能與免疫缺陷、反覆感染、遺傳性或者獲得性免疫障礙等因素導致T抑制細胞的缺失或功能障礙,免疫調節功能長期負荷,免疫細胞發生異常的增殖反應,最終出現無限增殖,導致發病。
(二)病機
本病由外火風燥,或寒痰疑滯,內因憂思喜怒,肝鬱氣結生痰化火及氣滯血瘀,積而成結,日久臟腑內虛,肝腎虧損,氣血兩虧。
1、邪毒鬱熱外受毒邪入侵,日久化熱化火,火熱傷氣,燒灼臟腑,是為邪熱火毒,毒蘊於內,日久發為癌瘤。
2、寒痰凝聚素體脾胃虛弱,水濕運化失常,水聚於內,津液不布,濕蘊於內,久成濕毒,濕毒泛濫,浸淫生瘡,流汁流水,經久不愈;津液不化與邪火熬灼,逐凝結為痰,久而成癌。
3、氣滯血瘀情志不舒,肝氣鬱結於內氣機不暢,氣滯血瘀,結而成結。
 何杰金氏淋巴瘤
何杰金氏淋巴瘤4、氣血兩虧正氣虛弱,臟腑乃虛,肝腎虧損,病邪日久,臟腑功能失調,氣血虧虛,損及元氣而發癌瘤。對何杰金氏淋巴瘤的發病機理,最受重視的是病毒病因學說研究,認為病毒尤其是能引起傳染性單核細胞增多症的EB病毒,可能與本病的發生有關。病毒病因雖受重視,但仍缺乏直接有利的左證。對本病發生起重要作用的有諸多因子:如免疫缺陷狀態(原發性免疫缺陷、器官移植後免疫抑制、各種疾病繼發的免疫紊亂)、輻射、藥物(烷化劑)及遺傳因素等。有外國學者認為本病是以;誘導腫瘤"的病毒感染開始,使淋巴組織持久增生,並引起胸腺系統淋巴細胞的表面抗原性改變。這種淋巴細胞又和正常T淋巴細胞相對抗,相互作用後導致腫瘤性網狀細胞和終末期的多核巨網細胞(即R-S細胞)形成,最後淋巴免疫耗竭而發生腫瘤。
非霍奇金氏淋巴瘤病因同何杰金氏淋巴瘤其病毒病因系統頗受重視,伯基特淋巴瘤發病卻與EB病毒感染相關,而常染色體隱性遺傳、器官移植後免疫仰制狀態等,都增加了淋巴瘤生成的可能性。另外,從事橡膠、石油提煉或觸砷、苯氧乙酸和氯酚與次病有關。
病理分型
何杰金氏淋巴瘤的病理學分型經歷了半個多世紀由淺到深的歷史過程。臨床採用的是Lukes和ButIes提出,又
 何杰金氏淋巴瘤
何杰金氏淋巴瘤類型R-S細胞病理學特點臨床特點
淋巴細胞較少見結節性浸潤,以小淋巴細胞為主診斷時臨床多為Ⅰ期或Ⅱ期,為主型預後相對較好
結節硬化型明顯可見結節樣結構,其間分布淋巴細此型臨床多為Ⅱ期或Ⅰ期,80%胞、漿細胞、中性細胞及嗜酸病人為35歲以下,女性多見。
性粒細胞國外報導此型是HD中之最多見者,預後相對較好
混合細胞型多見主要為淋巴細胞、漿細胞、中性此型常病變分布較廣,常累及腹粒細胞、嗜酸性粒細胞內淋巴結,預後較差
淋巴細胞消數量可多淋巴細胞少見,組織細胞浸潤此型臨床多為Ⅲ或Ⅳ期,多為老減型可少明顯年,病變擴散範圍廣,預後最差,病例亦少見
擴散轉移
大多數何杰金氏淋巴瘤患者其早期起源於淋巴系統的一個中心,即一個淋巴結區,尤其青年患者更是如此。少數病人早期就起源於淋巴系統的多箇中心。
病變擴散與轉移的途徑有三條:①從病變中心通過淋巴管向鄰近的淋巴組織轉移;②通過血液播散向遠處轉移;③病變直接向周圍組織及器官浸潤性蔓延生長。
臨床表現
HD分期的目的是為了明確病變的分布範圍和確切部位,這對決定採用的治療措施和估計預後有及其重要的意義,
 何杰金氏淋巴瘤CT圖
何杰金氏淋巴瘤CT圖HD的國際臨床分期(AnnArbor會議,1971)標準如下。
Ⅰ期:Ⅰ:單個淋巴結外器官區受侵犯。
ⅠE:單個結外器官或部位受侵犯
Ⅱ期:Ⅱ:在膈肌同側的兩組或多組淋巴結受侵。
ⅡE:在膈肌同側的一組或多組淋巴結受侵,伴發局部器官或部位同時受侵犯。
Ⅲ期:Ⅲ:膈上下淋巴結同時受侵犯
ⅢE:膈上下淋巴結同時受侵犯,同時伴有局限性結外器官或部位受侵犯。
Ⅲs:膈上下淋巴結同時受侵犯,同時伴有脾臟受侵犯。
ⅢsEⅢ+ⅢE+Ⅲs:一個或多個結外器官廣泛性或播散性侵犯,同時伴有局限性結外器官或部位受侵犯,受侵犯部位可用符號表示。肝受侵。
Ⅳ期:受侵犯-H+,肺受侵犯-L+,骨髓受侵犯-M+,皮膚受侵犯D+,胸膜受侵犯-P+,胃受侵犯-D+。
全身症狀分組:每組分為A、B兩組。凡有以下症狀者為B組,無以下症狀為A組。
1、發熱不是其它原因引起的,經常發熱38℃以上;
2、有盜汗;
3、體重減輕,無其他病因引起的體重減輕10%以上者。
結外器官是指除去淋巴結、脾臟、胸腺、扁桃體環、闌尾及Peyer淋巴結的器官和組織。
治療方案
HD的治療方法有方射治療、化學治療、中醫治療和其他輔助治療,如外科手術、免疫治療等。HD的治療原則:中醫藥貫穿治療始終並在治癒後堅持套用兩年左右。局部病變(Ⅰ、Ⅱ期)以放療為主。全身病變(Ⅲ、Ⅳ期)以化療為主。間或輔以手術治療、免疫治療。
根據臨床分期採用的治療方法為:
對Ⅰa、Ⅱa膈上病變,採用斗篷野放療加全淋巴結放療(上腹、主動脈旁、脾區)、不加化療。對Ⅰa、Ⅱa膈下病變,應採用倒Y野(包括脾蒂)放療(放療前作局部病變切除,脾切除療效更佳),不加化療。Ⅰa、Ⅱa膈上或膈下病變也可採用全部淋巴結放療,而不再加化療。Ⅲa採用全部淋巴結放療加化療。Ⅲb採用化療加主要病灶局部放療。Ⅳa、Ⅳb化療加主要病灶局部放療。
放射治療
放射治療是治療HD有效的主要方法之一。隨著科技水平的發展,高能量治療機如60CO治療機、直線加速器的問世,由於其照射劑量大,範圍廣,穿透能力強,顯著提高了HD的治癒路率。但其對照射野內的正常組織損傷也大,所以治療時應適當掌握照射劑量及範圍以減少併發症。
 何杰金氏淋巴瘤
何杰金氏淋巴瘤(一)放射劑量
1、腫瘤的殺滅劑量,通常每次放射劑量為2.0~2.5Gy,每周照射3~5次,總劑量40Gy,在5~6周內照射完畢。對於特別大或消失緩慢的淋巴結腫塊,局部可增至50Gy,5~7周。
2、預防性照射劑量,對於臨床上未發現病變的預防性照射區域,總劑量可至35Gy。
(二)放射的範圍
1、斗篷野
包括頸部、鎖骨上下、腋窩、縱隔、肺門淋巴結。需要保護喉頭、肱骨頭、肺、心臟、骨髓等器官。上界為兩側乳頭尖的連線;下界達第10胸椎體外2cm到第4胸椎下緣。注意患者體位定位時與治療時應完全一致;前野:仰臥位,頸下墊弧形木塊,使前後仰至下頜骨下緣上1cm與乳突之間聯線成一垂線,手心放於骼前上嵴處。後野:俯臥位,以頜尖著床,頭向後仰,使下頜骨下緣上1cm與乳突之間聯線成一垂直線,手心放於骼前上嵴處。
2、鋤形野
包括脾臟、腹主動脈旁淋巴結、骼總動脈旁淋巴結(後者國內常不包括)。上緣在第10胸椎下緣;下緣在第4胸椎下緣;外緣在錐體兩側各2cm。如包括脾臟其上緣為左側膈頂,下緣脾臟不大時在肋骨,脾大時需放1cm內緣與腹主動脈旁野相接,外緣在腹側壁。
3、盆腔野包括雙側骼動脈周圍和腹股溝淋巴結。上緣在第4腰椎下緣;下緣在股骨頭下7cm處,外緣在第4腰椎體外2cm上與髖臼外緣連線然後垂直向下;內緣從閉孔內緣至骶骼關節下緣2cm處。
4、倒Y野即鋤形野加盆腔野。
5、咽淋巴環野
不做模型,把照射野直接劃在病人皮膚上。上緣:顱底線上1cm;後緣:外耳孔前緣;下緣:下頜骨下緣上1cm,與斗篷野上緣相連線;前緣:與後緣平行,通過下頜骨水平的中心。
照射劑量45Gy/5~6周,必要是加量5~10Gy。斗篷野常用35~40Gy/4~5周在分野補量,兒童患者放療量20~30Gy/3~4周,但要加足量化療(6周期)。
化學治療
(一)聯合治療
來何杰金氏淋巴瘤的藥物治療有了很大進步,最主要是由於治療策略上的改進和有效化療方案的增多。許多學者報導對Ⅱ~Ⅳ期何杰金氏淋巴瘤患者的治癒率已超過50%。
 何杰金氏淋巴瘤
何杰金氏淋巴瘤以下為常用的治療何杰金氏淋巴瘤有效的聯合化療方案。
1、MOPP(COPP)方案
氮芥6mg/㎡(或環磷醯胺650mg/㎡),靜脈注射,第1、8天;
長春新鹼1.0~1.4mg/㎡,靜脈注射,第1、8天;
丙卡巴肼100mg/㎡,口服,第1~14天;
潑尼松40mg/㎡,口服,第1~14天。
14天為一周期,休息14天;通常給6個周期以上,潑尼松只在第1、4周期給予。
2、MNPP方案
氮芥6mg/㎡,靜脈注射,第1、8天;
長春新鹼6mg/㎡,靜脈注射,第1、8天;
丙卡巴肼100mg/㎡,口服,第1~14天;
潑尼松40mg/㎡,口服,第14天。
14天為一療程,休息28天;通常給6個周期以上,各周期均以給潑尼松。
3、ABVD方案
阿黴素25mg/㎡,靜脈注射,第1天;
博萊黴素10mg/㎡,靜脈注射,第1、14天;
長春新鹼6mg/㎡,靜脈注射,第1、14天;
達卡巴嗪150mg/㎡,靜脈注射,第1~5天。
14天為一周期,間隔14天。
4、VPP方案
環磷醯胺300mg/㎡,靜脈注射,第1、8天;
長春鹼10mg/㎡,靜脈注射,第1、8、15天;
丙卡巴肼100mg/㎡,口服,第1~15天;
潑尼松40mg/㎡,口服,第1~15天。
每42天重複一次,潑尼松只在第1、4周期時用,最少給6個周期。
5、B-CAVE方案
博萊黴素2.5mg/㎡,靜脈注射,第1、28、35天;
洛莫司汀100mg/㎡,口服,第1天;
長春鹼5mg/㎡,靜脈注射,第1天。
第6周重複一次,共9周期。與MOPP無交叉耐藥,對MOPP治療失敗的病人75%有效。
復發治療
即使HD的治療再適時,且病變範圍組織較局限,但任有一部分病人若干年後會復發。復發的部位可以在身體一組淋巴組織,或為原位,或為治療前病變部位的鄰近淋巴組織,或為遠距離轉移,或為身體廣泛轉移。如果復發前已接受過放療的HD病人,復發後再用MOPP方案,化療仍有較高的完全緩解率(70%~76%)。如果復發前曾用過化療或化療加放療,復發後再用化療則完全緩解率明顯下降。各種組織類型的復發病例均對MOPP方案有長期效果。
手術治療:過去曾對早期HD局限病變組織實行手術切除治療,由於療效並不比局部放療效果好,已不再使用。但外科手術治療作為特殊情況下的輔助治療還是使用的,比如拌有脾功能亢進、胃腸道病變等均可實行手術治療。尤其手術對HD的診斷與病理分析方面具有十分重要的意義。

